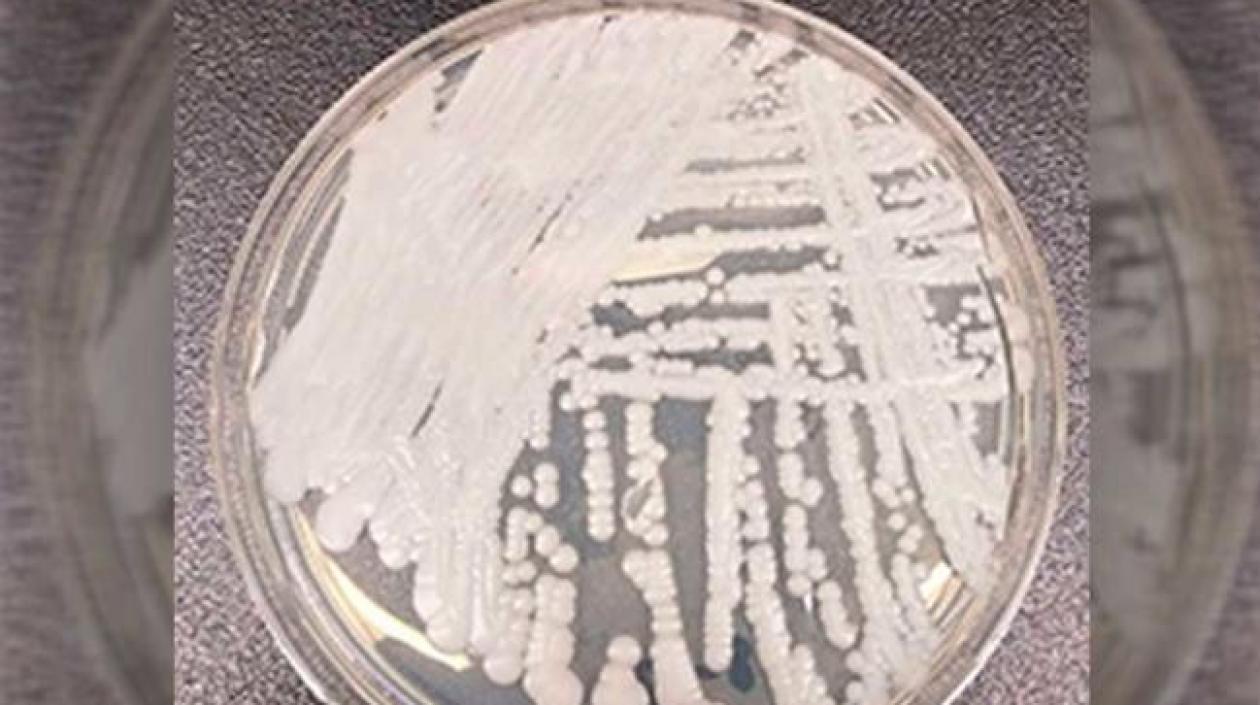
La Cándida auris apareció en 2015 y tiene vigilancia en Colombia desde el año 2016.

"No ha surgido ningún hongo nuevo que ponga en riesgo la salud de los colombianos": MinSalud sobre la Cándida auris
Este hongo se vigila en Colombia desde el año 2016.
El Ministerio de Salud y el Instituto Nacional de Salud (INS) informaron este miércoles que en Colombia no ha aparecido ningún hongo nuevo y mortal que afecte la salud de los colombianos. "Desde 2015 se conoce la presencia de Cándida auris y al año siguiente se incluyó su vigilancia en el Sistema Nacional de Vigilancia en Salud Pública (Sivigila)", sostuvo el Ministerio.
Explicaron que "la Cándida auris es una levadura usualmente intrahospitalaria, en ocasiones multirresistente. Puede contaminar el ambiente de las habitaciones en hospitalización general, Unidades de Cuidado Intensivo y salas de cirugía, entre otros, principalmente por baja adherencia a la higienización y lavado de manos, y por procesos deficientes de limpieza y desinfección de las diferentes áreas. Por lo general, este hongo afecta a personas con compromiso inmunológico, en especial aquellos con cáncer, enfermedad renal crónica, VIH/Sida y aquellos con hospitalizaciones prolongadas".
Reportes
Varios países han reportado la presencia de Cándida auris. La primera vez fue en Japón en 2009 y posteriormente en Corea del Sur, India, Sudáfrica, Kuwait, Israel, Omán, Estados Unidos, Canadá, Brasil, Reino Unido, Noruega, Alemania y España. En 2012 se notificó un brote hospitalario de esta levadura en Venezuela, el primero en las Américas.
En Colombia, desde 2015 se han identificado casos de infección por Cándida auris de forma aislada. "Entre el primero de enero y el 31 de marzo de este año se han notificado 64 casos; durante 2019 ni el Ministerio ni el INS han generado nuevas alertas epidemiológicas frente a este evento, ni han identificado muertes atribuibles a Cándida auris", indicó el comunicado del Ministerio de Salud.
Y añaden: "Aunque esta levadura presenta multirresistencia a los antifúngicos utilizados mundialmente, en Colombia no se ha presentado este comportamiento. El 99% de los aislamientos efectuados respondieron adecuadamente a los medicamentos antifúngicos".
Las acciones de vigilancia, control de brotes y prevención de nuevos casos de infecciones invasivas causadas por Cándida auris, en particular aquellas emitidas en la Circular Externa Conjunta 025 del 26 de julio de 2017 del Ministerio de Salud y Protección Social y el INS, están a cargo de las secretarías de Salud Departamentales, Distritales y Municipales, las Empresas Administradoras de Planes de Beneficios, las Instituciones Prestadoras de Servicios de Salud, Asociaciones Científicas y Universidades. Así mismo, deben continuar con el cumplimiento del protocolo de Vigilancia en Salud Pública de Infecciones Asociadas a la Atención en Salud (IAAS) del INS.




